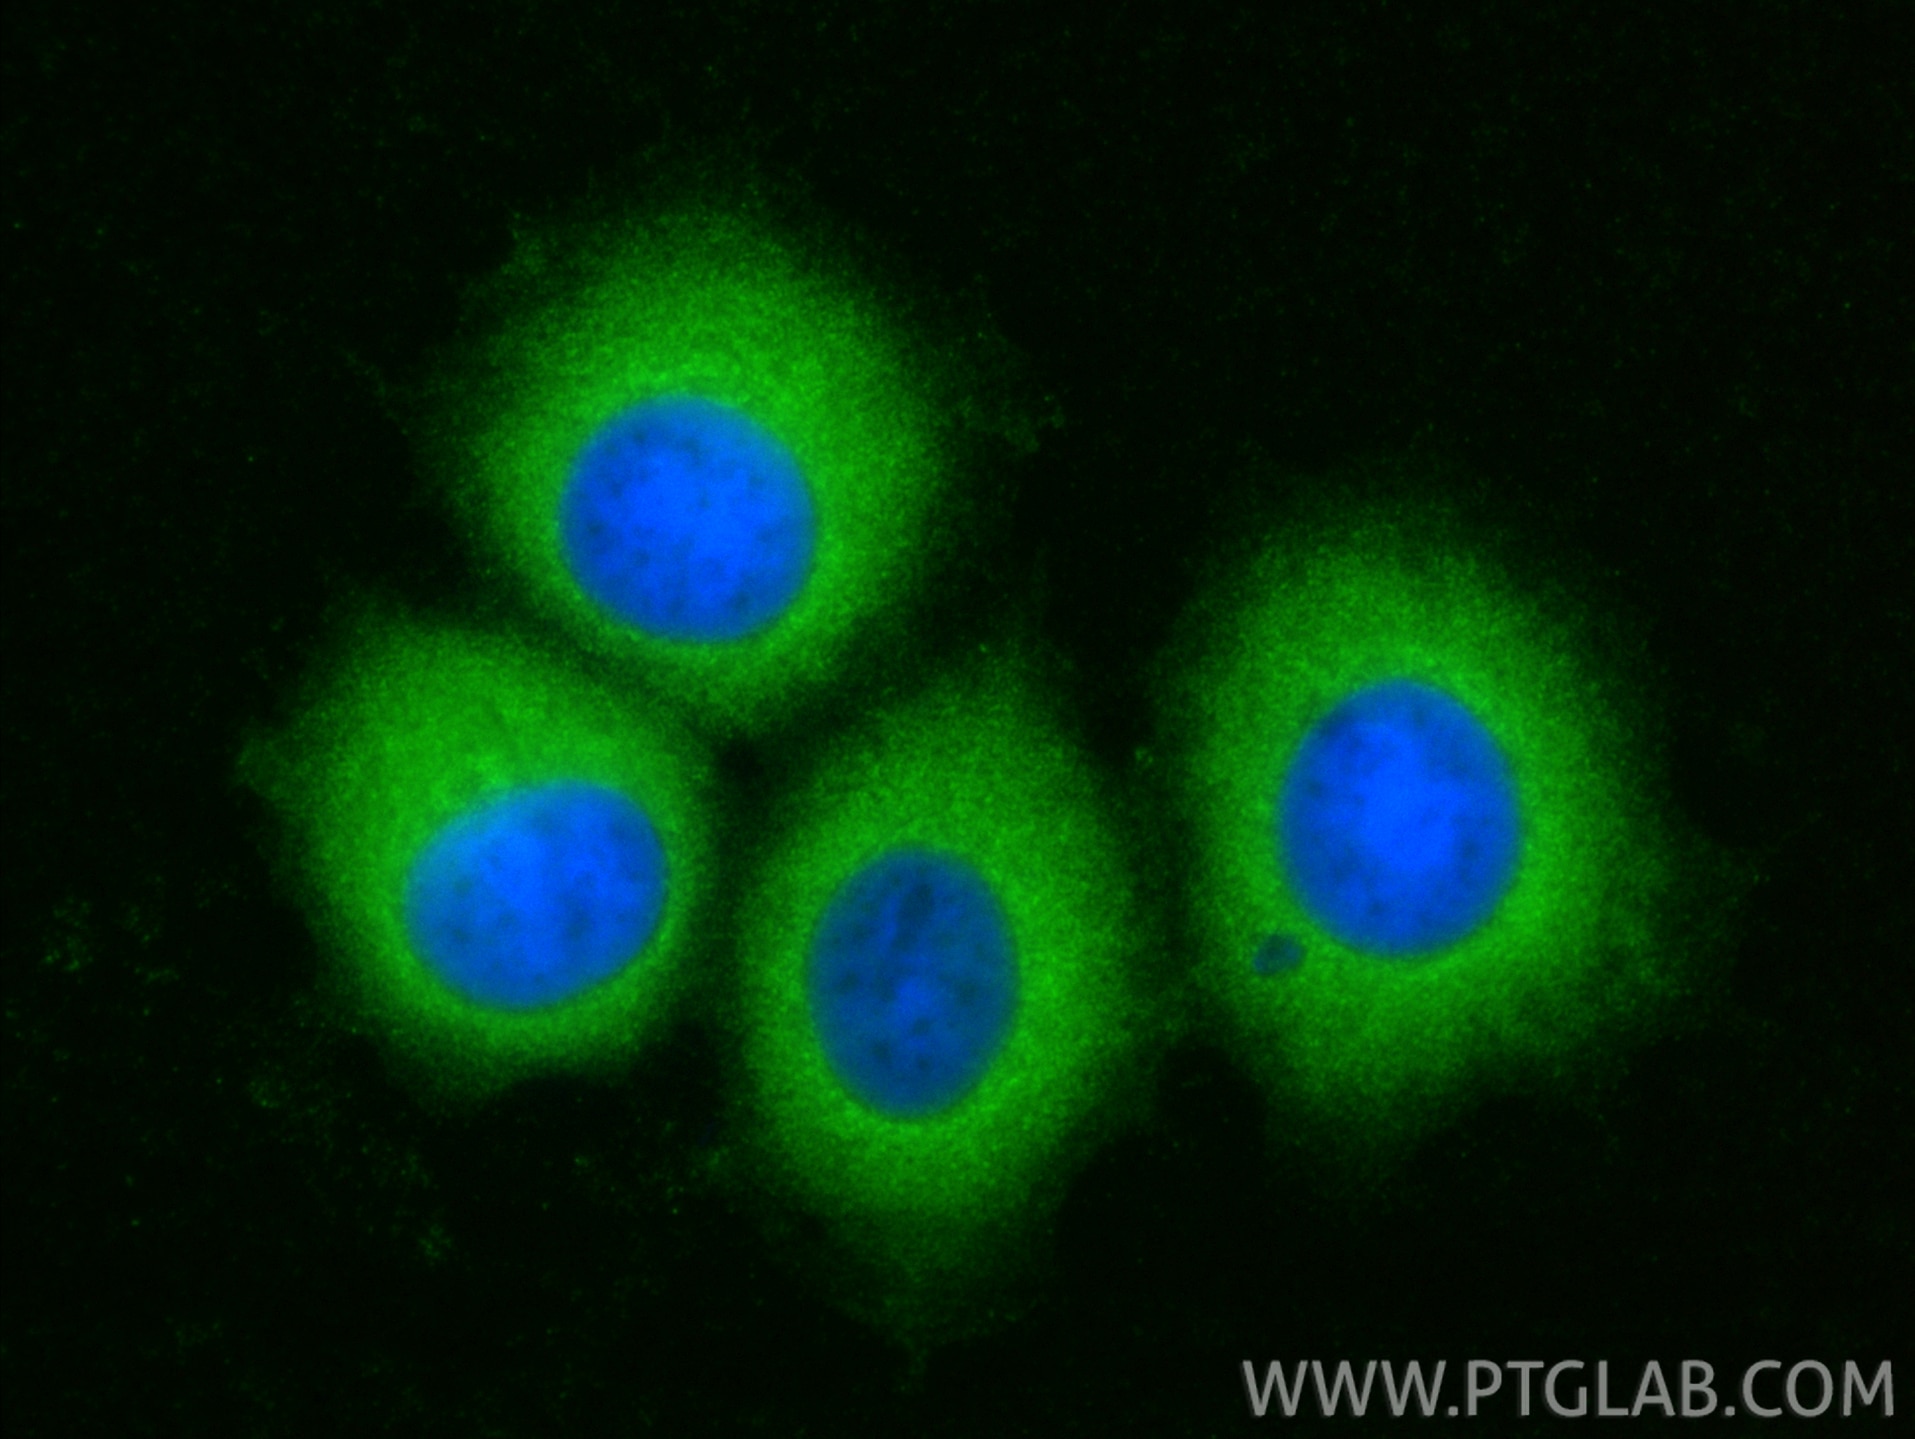
Immunofluorescence (IF) / fluorescent staining of MCF-7 cells using TCP1 eta Polyclonal antibody (15994-1-AP)

Tested Applications
| Positive WB detected in | HEK-293 cells, HeLa cells, MCF-7 cells, MDA-MB-231 cells |
| Positive IP detected in | HEK-293 cells |
| Positive IF/ICC detected in | MCF-7 cells |
Recommended dilution
| Application | Dilution |
|---|---|
| Western Blot (WB) | WB : 1:2000-1:12000 |
| Immunoprecipitation (IP) | IP : 0.5-4.0 ug for 1.0-3.0 mg of total protein lysate |
| Immunofluorescence (IF)/ICC | IF/ICC : 1:400-1:1600 |
| It is recommended that this reagent should be titrated in each testing system to obtain optimal results. | |
| Sample-dependent, Check data in validation data gallery. | |
Published Applications
| WB | See 7 publications below |
| IHC | See 2 publications below |
| CoIP | See 1 publications below |
Product Information
15994-1-AP targets TCP1 eta in WB, IHC, IF/ICC, IP, CoIP, ELISA applications and shows reactivity with human, mouse, rat samples.
| Tested Reactivity | human, mouse, rat |
| Cited Reactivity | human, mouse, chicken |
| Host / Isotype | Rabbit / IgG |
| Class | Polyclonal |
| Type | Antibody |
| Immunogen |
CatNo: Ag8868 Product name: Recombinant human CCT7 protein Source: e coli.-derived, PGEX-4T Tag: GST Domain: 240-543 aa of BC019296 Sequence: LNVELELKAEKDNAEIRVHTVEDYQAIVDAEWNILYDKLEKIHHSGAKVVLSKLPIGDVATQYFADRDMFCAGRVPEEDLKRTMMACGGSIQTSVNALSADVLGRCQVFEETQIGGERYNFFTGCPKAKTCTFILRGGAEQFMEETERSLHDAIMIVRRAIKNDSVVAGGGAIEMELSKYLRDYSRTIPGKQQLLIGAYAKALEIIPRQLCDNAGFDATNILNKLRARHAQGGTWYGVDINNEDIADNFEAFVWEPAMVRINALTAASEAACLIVSVDETIKNPRSTVDAPTAAGRGRGRGRPH Predict reactive species |
| Full Name | chaperonin containing TCP1, subunit 7 (eta) |
| Calculated Molecular Weight | 543 aa, 59 kDa |
| Observed Molecular Weight | 59 kDa |
| GenBank Accession Number | BC019296 |
| Gene Symbol | CCT7 |
| Gene ID (NCBI) | 10574 |
| RRID | AB_2073903 |
| Conjugate | Unconjugated |
| Form | Liquid |
| Purification Method | Antigen affinity purification |
| UNIPROT ID | Q99832 |
| Storage Buffer | PBS with 0.02% sodium azide and 50% glycerol, pH 7.3. |
| Storage Conditions | Store at -20°C. Stable for one year after shipment. Aliquoting is unnecessary for -20oC storage. 20ul sizes contain 0.1% BSA. |
Background Information
CCT7 is a subunit of CCT complex-a large cytosolic chaperonin complex composed of two hetero-oligomeric stacked rings able to interact with nascent polypeptides, which mediates protein folding in an ATP-dependent manner and prevents aggregation in eukaryotes. Each ring consists of eight different subunits (CCT1 to CCT8). CCT7 is involved in preventing aggregation of GPCRs and in regulating their expression, maturation, and transport to the cell surface.
Protocols
| Product Specific Protocols | |
|---|---|
| IF protocol for TCP1 eta antibody 15994-1-AP | Download protocol |
| IP protocol for TCP1 eta antibody 15994-1-AP | Download protocol |
| WB protocol for TCP1 eta antibody 15994-1-AP | Download protocol |
| Standard Protocols | |
|---|---|
| Click here to view our Standard Protocols |
Publications
| Species | Application | Title |
|---|---|---|
Nat Commun Tick extracellular vesicles enable arthropod feeding and promote distinct outcomes of bacterial infection. | ||
Aging (Albany NY) Overexpression of chaperonin containing TCP1 subunit 7 has diagnostic and prognostic value for hepatocellular carcinoma. | ||
Virology Murine cytomegalovirus M72 promotes acute virus replication in vivo and is a substrate of the TRiC/CCT complex. | ||
Medicine (Baltimore) Chaperonin-containing TCP-1 subunit genes are potential prognostic biomarkers and are correlated with Th2 cell infiltration in lung adenocarcinoma: An observational study | ||
Mol Cell FACS-based genome-wide CRISPR screens define key regulators of DNA damage signaling pathways |